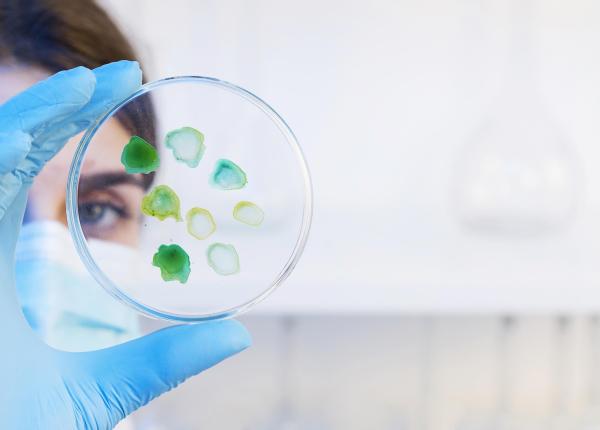

Anatomie Patologică/Analize de laborator
EXCLUSIV Testul care îți arată dacă faci cancer. Prof. univ. dr. Ovidiu Pop: Cifre impresionante
EXCLUSIV Consumatorii de droguri ”sunt niște carcase ambulante, zombi”. Dr. Radu Țincu: Societatea va fi alcătuită din persoane disfuncționale
Vârsta consumatorilor de substanțe psihoactive a scăzut la 9-10 ani. Dr. Radu Țincu trage un semnal de alarmă.
Testosteronul scăzut, asociat cu un risc crescut de deces. Poate provoca și boli cardiovasculare
Această analiză îți poate arăta riscul de mortalitate. De asemenea, o valoare scăzută poate duce la boli cardiovasculare.
EXCLUSIV Valoarea la care se consideră că ai colesterolul mărit. Dr. Sorin Băilă: Este foarte, foarte mult. Nu e normal să ajungem aici
Care e valoarea de la care se consideră că ai colesterolul mărit. Cum poate fi prevenit.
Modificarea unei singure gene, responsabilă de apariția cancerului. Rolul crucial al genei BAP1 în dezvoltarea cancerului
O singură genă poate genera peste 5.000 de variante genetice care permit cancerului să se dezvolte necontrolat.
Galleri, testul care detectează cancerul în stadiile incipiente. Identifică 80% din cancerele pentru care nu există screening
Galleri este testul de sânge care detectează cancerul în stadiile incipiente. Detectează peste 50 de tipuri de cancer.
Ce înseamnă dacă ai bilirubina mărită. Afecțiunile pe care le indică
Colesterolul mărit, asociat cu o afecțiune dureroasă. Simptomele, tulburătoare
Colesterolul mărit este asociat cu o afecțiune dureroasă, tulburătoare.
Testul care îți arată dacă ai deficit de Vitamina D. Care sunt complicațiile asociate cu un nivel scăzut de Vitamina D
Acest test îți poate arăta dacă ai deficit de Vitamina D. Complicațiile deficitului de Vitamina D sunt majore.
Nutrientul lipsă care pune viața în pericol. Efecte mai nocive decât fumatul
Lipsa acestui nutrient poate pune viața în pericol. Este considerat mai nociv decât fumatul. Crește riscul de moarte prematură.
Semnul care îți arată că ai colesterolul mărit. Efectele, catastrofale
Semnul care arată debutul bolii Alzheimer. Nu este vorba de pierderile de memorie
Acest indiciu nou ar putea semnala boala Alzheimer înainte de apariția simptomelor.
Analiza esențială înainte de operație. Prof. dr. Daniela Filipescu: Un mare beneficiu pentru pacient
Aceasta este analiza esențială înainte de o intervenție chirurgicală. Duce la o evoluție favorabilă post-operatorie.
EXCLUSIV Deliciul de pe masa de Paște care are efecte psihoactive. Dr. Cristian Paparău: Nu ar trebui să ne mire. Se pozitivează la fel ca la un consumator de droguri de mare risc
Testul care depistează boala Alzheimer înainte de apariția primelor simptome. Eficacitate ridicată și metodă non-invazivă
Testul care depistează boala Alzheimer înainte de apariția primelor simptome este non-invaziv și are o acuratețe ridicată.
Cele două senzații pe care le simt oamenii înainte de moarte. Sunt cele mai des întâlnire. Nu este vorba de durere
Testul care identifică 18 tipuri de cancer. Detectează tumorile în stadiile incipiente cu o precizie ridicată
Ce văd muribunzii în ultimele clipe. Ce se întâmplă în creier atunci când murim
Testul de sânge care arată dacă ai cancer. Descoperirea revoluționară care poate detecta celulele canceroase din fază incipientă
Testul de sânge care arată dacă ai cancer. Este supranumit ucigașul tăcut.
Drug Test, rezultate false. Vlad Zaha (criminolog): Au fost situații în care șoferii doar au mâncat covrigi cu mac
EXCLUSIV Alcooltest: cum poți să ai rezultat pozitiv deși nu ai consumat alcool. Cristian Paparau: Să solicitați recoltare de sânge
Cele trei boli care distrug rinichii. Analizele care îți arată dacă ai probleme renale sunt gratuite. Alexandru Rafila: La început nu se manifestă. Este o boală tăcută
Analizele care îți arată dacă ai cancer. Fac parte din testele uzuale
Testele care îți arată dacă ai probleme cu ficatul. Când sunt recomandate
EXCLUSIV De ce avem impresia că persoanele decedate zâmbesc. Ce este rigor mortis. Cristian Paparau: Este un semn al morții reale
De ce avem impresia că persoanele decedate zâmbesc. Ce se petrece, de fapt, după deces.
Testul care îți arată dacă ai deficit de Vitamina D. Cum se manifestă simptomele și care sunt efectele pe termen lung
Testul care îți arată dacă ai deficit de Vitamina D se poate realiza la orice laborator de analize medicale.
Trombocitele scăzute, semn al unei afecțiuni a măduvei osoase. Indică și o funcționare necorepunzătoare a splinei. Vânătăile sau sângerările, primele simptome
EXCLUSIV Ce droguri au fost găsite la UNTOLD și ce efecte dau. Medicamente cu prescripție medicală, folosite de tineri. Cristian Paparau: Creează o distorsiune a percepției
Ce droguri au fost găsite la UNTOLD și care este efectul acestora. Pastilele cu prescripție medicală, folosite ca droguri.
Cine trebuie să ia IOD în caz de atac nuclear. De ce persoanele peste 40 de ani nu pot lua iodura de potasiu. Tot ce trebuie să știi în caz de radiații radioactive
Cine trebuie să ia IOD în caz de atac nuclear. Ce trebuie să faci în cazul unui astfel de dezastru.
Lucrurile pe care trebuie să le știi despre biopsie. Ce trebuie să faci înainte, în timpul și după intervenție. Cât de concludente sunt rezultatele
Robert De Niro, tată la 79 de ani. Când sunt bărbații mai fertili și ce se întâmplă dacă faci copii după 34 de ani
Robert De Niro a devenit tată la 79 de ani. Cum influențează vârsta fertilitatea masculină.
EXCLUSIV Certificatul de virginitate, eliminat oficial. Ana Măiță: O aberație că a existat! Erai dusă să fii chinuită de mama și tata. Lăsa o traumă
Certificatul de virginitate a fost eliminat. Ordinul a fost publicat în Monitorul Oficial.
Ce este fentanilul, substanța care l-a ucis pe rapperul Coolio. Cui îi este prescris
Ce este fentanilul, substanța care l-a ucis pe rapperul Coolio. Cui îi este prescris și cum se administrează.
EXCLUSIV Analize de sânge, amprente și ADN: ce trebuie să știi despre fiecare. Ce se folosește pentru testul de paternitate. Curcă: Este cea mai importantă
Ce trebuie să știi despre analizele de sânge, amprente sau ADN. Care oferă o acuratețe ridicată în cazul unor teste.
EXCLUSIV Expertizele medico-legale: când și cui se cer. Curcă, despre lege și experții independenți: Egalitate de "arme". Poți contrazice concluziile
Expertizele medico-legale pot fi solicitate în mai multe cazuri. În anumite situații acestea pot fi contestate. Care este procedura.
EXCLUSIV Drug Test, erori și lacune. Ce este benzodiazepina, găsită la Ana Morodan. Paparau: Singura probă luată în considerare de instanță! Sunt necesare sancțiuni mai grave
Anemia, cauze și simptome. Nica: Întâlnim complicații precum leșin, insuficiență coronariană sau respiratorie
EXCLUSIV Terapiile inovative, efect major. Coliță: Corectitudine a răspunsului terapeutic
Terapiile inovative își fac loc și în marile centre universitare din țară. Ce beneficii aduc pentru pacienți.
Cancerul, depistat prin teste genetice. Rădoi: Oferim pacientului tratament personalizat
Cancerul poate fi depistat prin anumite teste genetice. Cum se realizează acestea și care este beneficiul pentru pacienții oncologici.
EXCLUSIV Ce se întâmplă dacă bei 44 de pahare de vin conform tradiției. Paparau: E greu de crezut. Comă alcoolică sau deces
Ce se întâmplă dacă bei 44 de pahare de vin. Care sunt riscurile la care te expui.
EXCLUSIV Canabisul, ilegal, dar neincriminat. Paparau: Cum îți poate strica un joint viitorul? De aici începe partea horror
EXCLUSIV Boala care afectează doar bărbații. Alexei Romanov, diagnosticat. Herghelegiu: Simptomele pot fi severe
EXCLUSIV Testele genetice în sarcină, când și cui sunt recomandate. Herghelegiu: Se analizează întregul ADN. În cazul bolilor genetice nu există tratament. Nu putem schimba ADN-ul
Testele genetice efectuate de femeia însărcinată pot oferi informații despre anumite boli de care ar putea suferi copilul.
Eritrocitele, ce sunt și care este rolul lor. Indică o inflamație în organism. Ce boli poți avea
Creatinina, care sunt valorile normale. Ce se întâmplă dacă este prea mare sau mică
Creatinina scăzută poate indica o problemă la nivelul mușchilor sau al ficatului.
Clostridium perfringens, bacteria identificată în Dunăre. Te poți îmbolnăvi într-un mod foarte simplu
Clostridium perfringens este o bacterie descoperită în Dunăre. Poate provoca afecțiuni grave.
EXCLUSIV Aragazul, nociv și interzis în UE. Cum distruge întreaga lume. Atenție la asta când gătești. Paparau: Asta reduce oxigenul respirat! În România mulți se încălzesc direct la flacăra aragazului
Colesterolul mărit, afecțiune fără simptome evidente. Care sunt semnele discrete la care să fii atent. Care sunt valorile normale
Colesterolul mărit stă la baza unor afecțiuni care vă pot pune viața în pericol. Află care sunt semnele pe care le transmite organismul.
EXCLUSIV De la ce vârstă începe bătrânețea. Diana Bulgaru: Moartea de bătrânețe NU există! Nu se scrie niciodată așa ceva. La așa vârstă nu poți spune că a murit de bătrân
Moartea de bătrânețe este o sintagmă des utilizată. Dar, totuși, ce spun specialiștii despre moartea de bătrânețe.
-
Legătura surprinzătoare dintre somn, intestin și inimă
12 iun 2026, 22:09 -
-
Greșeala pe care o faci când îmbraci hainele noi
12 iun 2026, 20:18 -
-
De ce unele medicamente nu se iau niciodată cu lapte sau iaurt
12 iun 2026, 17:34